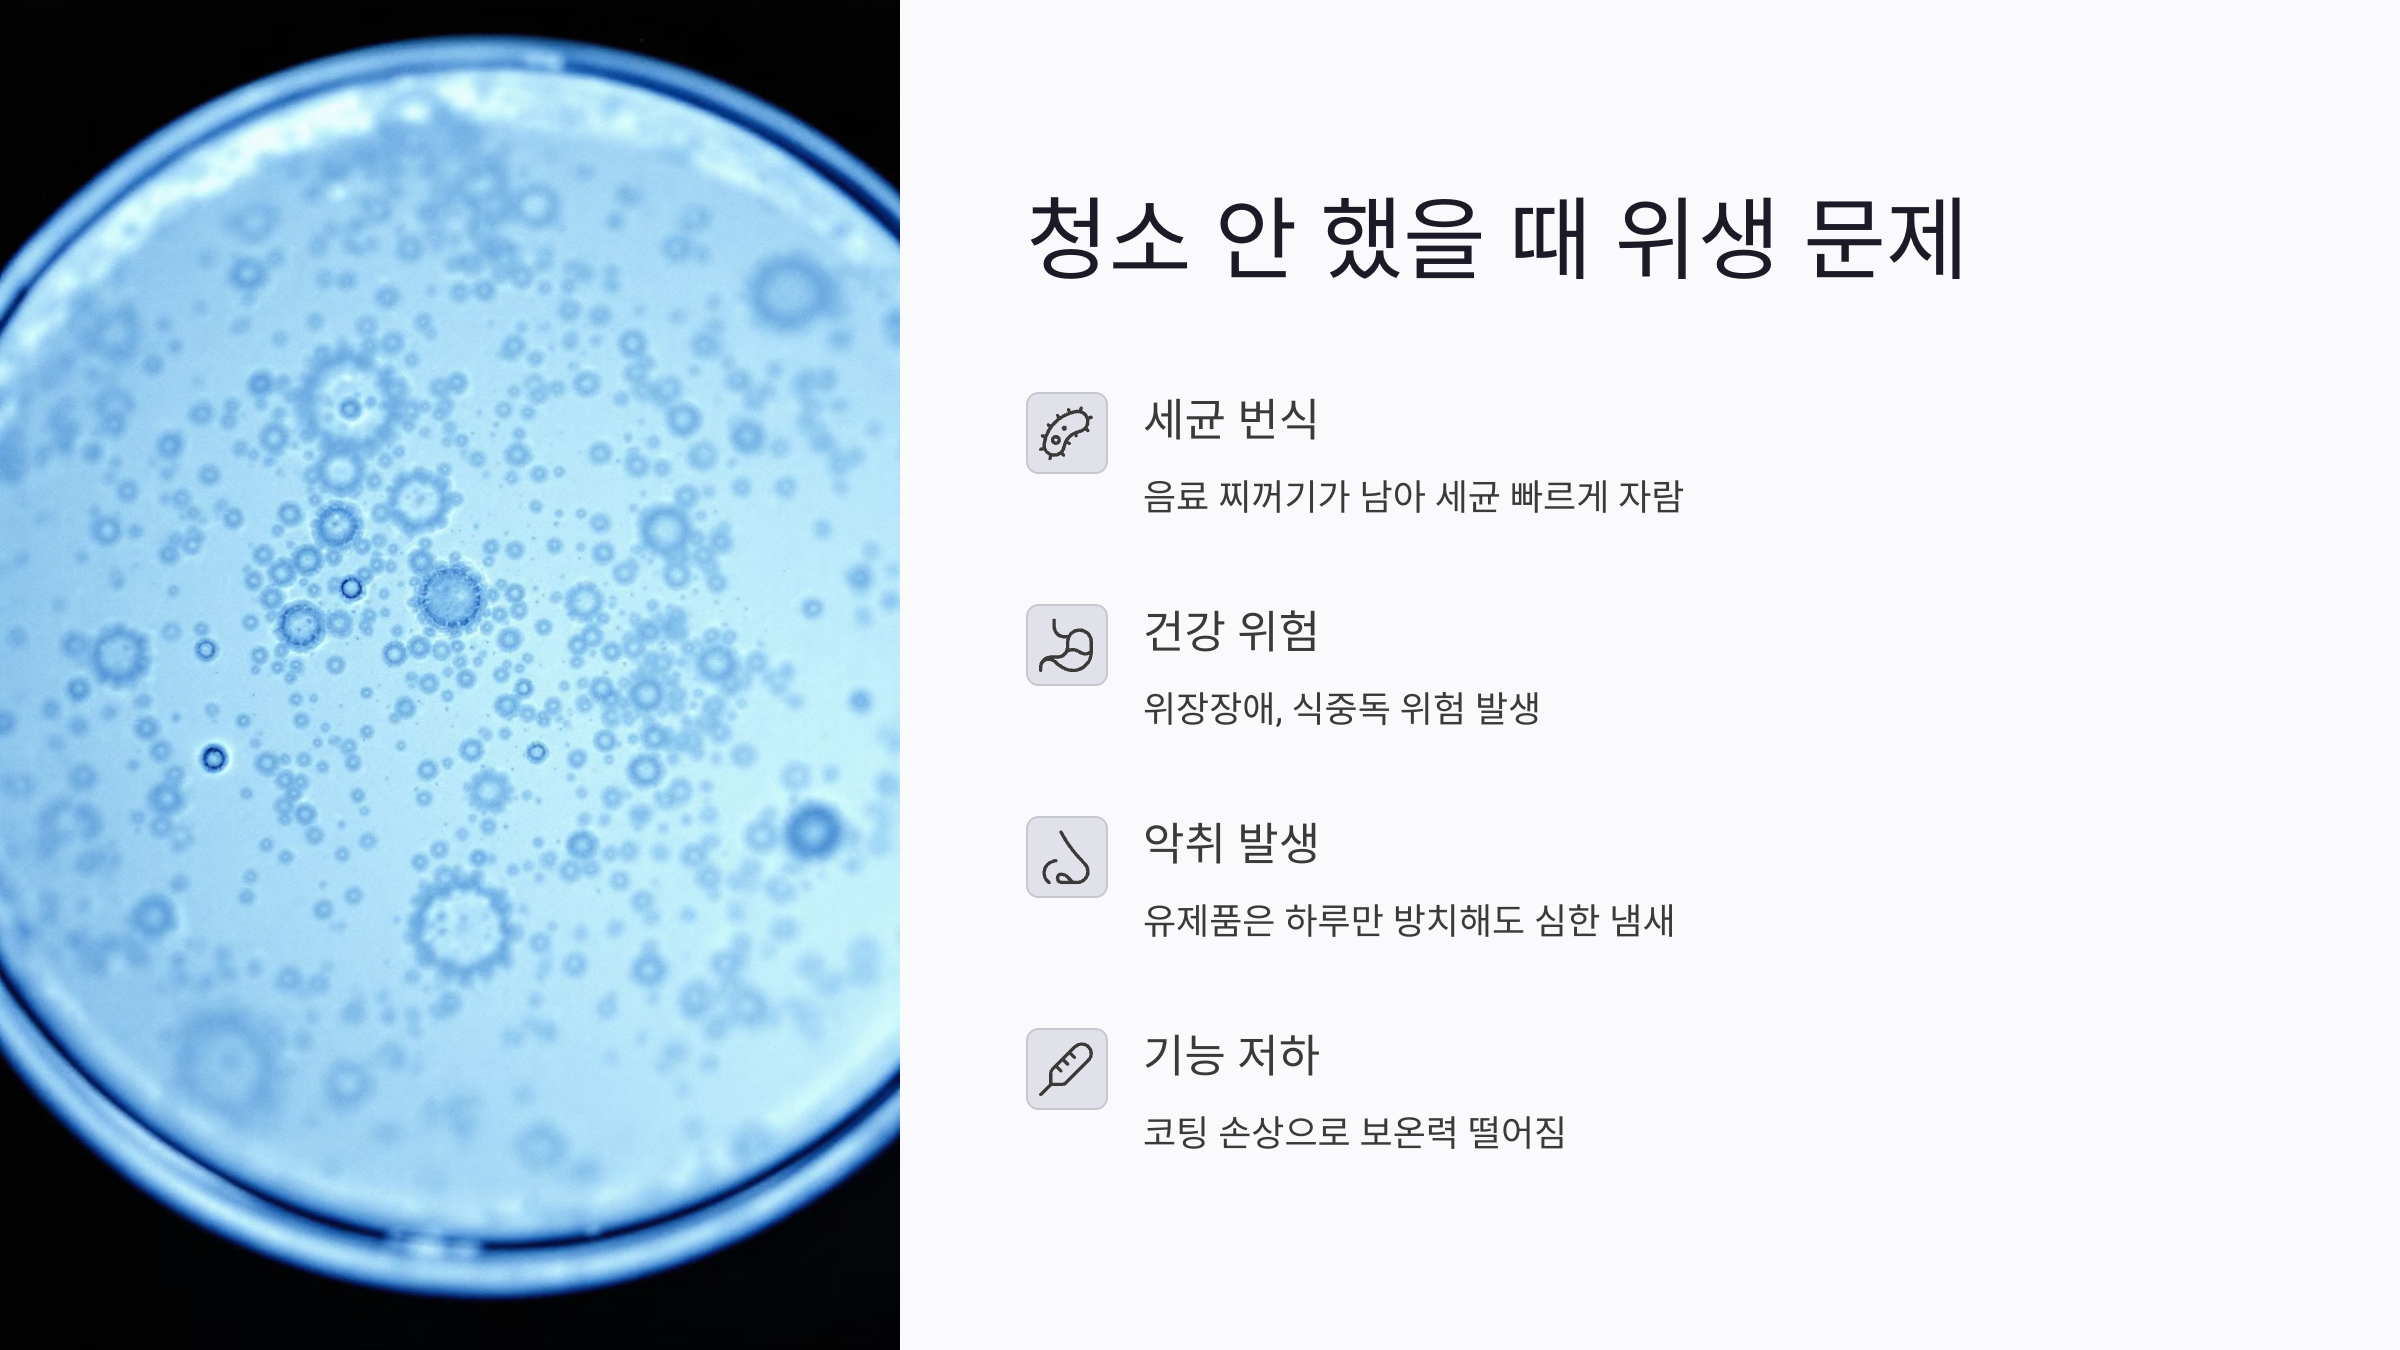
텀블러 청소 안 했을 때 생기는 위생 문제

텀블러 청소 안 하면 생기는 일? 냄새·세균 막는 올바른 세척법 총정리
텀블러에서 냄새가 나거나 세균 걱정된 적 있으셨나요? 매일 입을 대고 사용하는 텀블러는 위생 관리가 생명입니다. 하지만 생각보다 많은 분들이 잘못된 방법으로 세척하거나, 청소 자체를 소홀히 하며 사용합니다. 이 글에서는 텀블러를 제대로 청소하지 않을 때 생기는 문제부터 세균을 막는 관리법, 냄새 제거 팁, 효과적인 세척용품 추천까지 자세히 안내해드립니다. 위생과 보온력을 오래 유지하고 싶다면, 꼭 확인해보세요.
✅텀블러 청소 안 했을 때 생기는 위생 문제
텀블러를 청소하지 않고 계속 사용하면 가장 먼저 생기는 문제가 세균 번식입니다. 입에 직접 닿는 뚜껑, 고무 패킹, 내부 벽면 등에 음료 찌꺼기가 남아 있으면 습기와 열기가 만나 세균이 빠르게 자랍니다.
보이지 않는 곰팡이와 세균이 내부에서 증식하면 위장장애, 입 냄새, 심할 경우 식중독 위험까지 생길 수 있습니다. 특히 우유나 유제품 계열 음료를 자주 넣는 경우엔 하루만 방치해도 악취가 심하게 발생합니다.
또한 청소가 제대로 되지 않으면 냄새가 배어드는 것은 물론이고, 스테인리스 내부의 코팅이 손상되며 보온력까지 떨어지게 됩니다. 결국 텀블러 본연의 기능을 잃고 수명을 단축시키는 결과로 이어집니다.
✅텀블러 세척 도구와 브러시 추천
깨끗한 세척을 위해서는 적절한 도구를 사용하는 것이 가장 중요합니다. 일반 수세미로는 텀블러 깊숙한 부분까지 닿지 않기 때문에 전용 브러시나 병 세척 도구가 필수입니다.
⚙️병 전용 브러시의 장점
길고 유연한 브러시는 텀블러 깊은 곳까지 손쉽게 닿을 수 있습니다. 끝이 부드러운 실리콘 소재라면 흠집 없이 스테인리스 내부를 안전하게 닦을 수 있습니다. 무엇보다도 거품이 풍부하게 생겨 세척력이 뛰어납니다.
⚙️고무 패킹 전용 솔
뚜껑이나 잠금장치 부분은 미세한 틈이 많아 세균이 잘 남습니다. 이럴 때는 작은 미니 브러시나 전용 솔로 패킹을 분리해 꼼꼼히 닦아야 위생이 유지됩니다. 고무 패킹은 뜨거운 물에 삶기보다는 브러시로 살살 문질러 세척하는 것이 좋습니다.
⚙️세척제 활용
중성세제 외에도 텀블러 전용 클렌저나 베이킹소다, 구연산 등이 효과적입니다. 세제를 사용할 때는 반드시 충분히 헹궈 잔류 세제가 남지 않도록 주의하세요.

✅텀블러 잘못된 세척법과 주의사항
간편하다는 이유로 텀블러를 물로만 헹구거나, 전자레인지에 돌리거나, 뜨거운 물에 오래 담가두는 습관은 오히려 제품을 망가뜨릴 수 있습니다. 잘못된 세척 방법은 위생을 해칠 뿐 아니라 텀블러 성능을 떨어뜨리게 됩니다.
⚙️뜨거운 물 담그기
고무 패킹은 열에 약하기 때문에 뜨거운 물에 오래 담가두면 형태가 변형될 수 있습니다. 패킹이 느슨해지면 누수가 생기고 밀폐력이 떨어집니다.
⚙️뚜껑을 덮은 채 건조
세척 후 뚜껑을 덮은 채 말리는 경우 내부에 수분이 갇히며 곰팡이와 악취가 생기기 쉽습니다. 반드시 뚜껑과 본체를 분리해 바람이 잘 통하는 곳에서 말려야 합니다.
⚙️세제 없이 물로만 헹구기
물로만 헹구는 것은 찌꺼기나 기름기를 제거하기에 충분하지 않습니다. 특히 커피나 음료 잔여물이 남으면 곧장 악취로 이어질 수 있으므로 반드시 세제를 활용한 세척이 필요합니다.
보온력 좋은 텀블러 추천 2025: 스테인리스 vs 플라스틱 비교와 성능 순위
보온력이 오래가는 텀블러를 찾고 계셨나요? 스테인리스 텀블러와 플라스틱 텀블러의 차이, 브랜드별 성능, 그리고 커피 맛을 살리는 팁까지 모두 모았습니다. 이 글을 통해 어떤 텀블러가 내
fivesh.com
✅세균 번식 막는 텀블러 관리법
위생적인 텀블러 사용을 위해서는 일정한 주기로 철저한 관리를 해야 합니다. 매일 사용하는 경우에는 간단 세척을, 일주일에 한 번은 깊은 세척을 권장합니다.
⚙️일일 세척 루틴
사용 후에는 중성세제와 전용 브러시로 바로 세척하고, 뚜껑과 패킹을 분리해 말려주세요. 한 번이라도 음료가 들어간 상태로 오래 방치되면 세균이 쉽게 번식할 수 있습니다.
⚙️주간 세척 루틴
주 1회는 베이킹소다 또는 식초를 활용한 자연 세정이 좋습니다. 텀블러 안에 미지근한 물과 베이킹소다 한 스푼을 넣고 30분 정도 두었다가 브러시로 세척하면 찌든 때와 냄새를 동시에 제거할 수 있습니다.
⚙️보관 시 주의사항
사용하지 않을 때는 뚜껑을 열어둔 채로 보관해 통풍이 잘 되도록 해야 하며, 습기가 많은 장소는 피해야 합니다. 밀폐된 곳에 두면 곰팡이 냄새가 다시 배일 수 있습니다.
✅텀블러 세척 루틴 비교표
| 관리 주기 | 권장 내용 | 주의할 점 |
|---|---|---|
| 매일 | 중성세제로 세척, 패킹 분리 후 건조 | 뚜껑 닫은 채 보관 금지 |
| 주 1회 | 베이킹소다 또는 식초로 깊은 세척 | 충분한 헹굼과 완전 건조 필수 |
| 장기 미사용 시 | 내부 건조 후 개방 보관 | 습한 환경 피하기, 악취 예방 필수 |
✅세균 잘 숨는 텀블러 뚜껑 청소 요령
뚜껑은 텀블러 중에서 가장 세균이 번식하기 쉬운 부위입니다. 내부에 고무 패킹이 끼워져 있고, 일부 제품은 잠금장치 구조로 세척이 어려운 경우가 많습니다.
청소 전에는 반드시 뚜껑을 분리하고, 패킹도 탈착한 후 개별적으로 세척해야 합니다. 칫솔처럼 얇고 뻣뻣한 미니 브러시를 활용하면 틈새까지 닦기 좋습니다. 뚜껑과 패킹은 세척 후 마른 천으로 수분을 제거하고, 그늘에서 완전히 말린 뒤 보관하세요.
패킹은 3~6개월에 한 번씩 교체하는 것이 위생 관리에 도움이 됩니다. 실리콘이 늘어지거나 색이 변한 경우는 바로 교체를 고려하세요.
✅텀블러 냄새 제거하는 법: 자연 탈취법 정리
텀블러에서 커피, 우유, 주스 냄새가 오래 남아있는 경우 단순 세척만으로는 해결되지 않는 경우가 많습니다. 이런 상황에는 자연적인 탈취법을 활용하는 것이 효과적입니다.
⚙️베이킹소다 활용법
텀블러에 따뜻한 물과 베이킹소다를 넣고 1시간 정도 둡니다. 이후 브러시로 내부를 닦고, 흐르는 물에 충분히 헹궈내면 냄새가 상당히 줄어듭니다.
⚙️식초와 구연산 활용
베이킹소다 후 식초를 소량 넣어 중화시킨 다음 헹궈주면 세균 제거와 탈취 효과를 동시에 얻을 수 있습니다. 구연산은 물때 제거에도 효과적이기 때문에 냄새뿐 아니라 이물질 제거에도 유리합니다.
⚙️천연 재료 이용
녹차 티백이나 레몬 조각을 텀블러에 넣고 하루 정도 둬도 냄새를 잡는 데 효과적입니다. 모든 탈취 과정 후에는 반드시 텀블러를 완전히 건조해야 탈취 효과가 유지됩니다.
✅브랜드별 텀블러 세척 난이도 비교
| 브랜드 | 세척 난이도 | 패킹 분리 가능 여부 | 뚜껑 구조 특징 |
|---|---|---|---|
| 락앤락 | 쉬움 | 가능 | 간단한 돌림식, 청소 간편 |
| 코멕스 | 쉬움 | 가능 | 분리형 뚜껑, 세척 편리 |
| 스탠리 | 중간 | 일부 가능 | 버튼형 뚜껑 구조로 틈새 청소 필요 |
| 예티(Yeti) | 어려움 | 제한적 | 고정형 구조 많아 브러시 필수 사용 필요 |
댓글